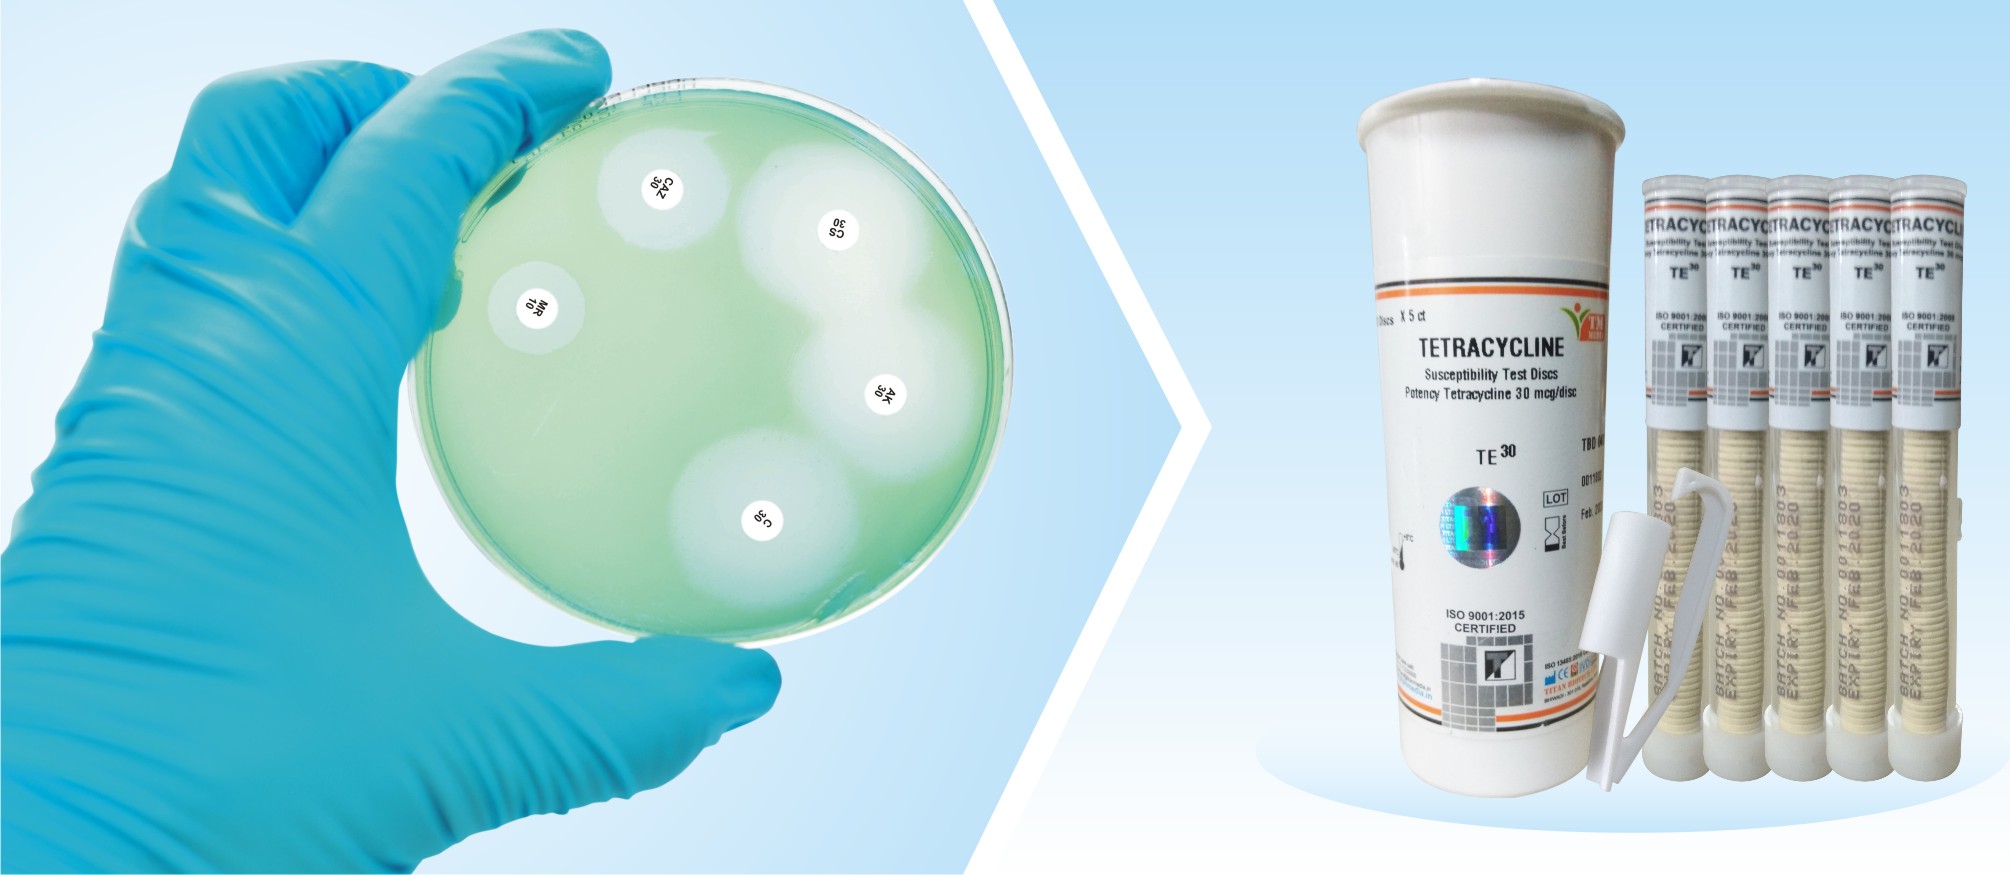

Cartridges containing commercially prepared antimicrobial discs for susceptibility testing are generally packaged to ensure appropriate anhydrous conditions.
Temperature and moisture are the most critical parameters affecting antimicrobial discs’ performance. Many antimicrobial agents are temperature sensitive, and moisture is a major cause of antibiotic degradation, so one should ensure careful handling of antimicrobial discs during transportation, storage, and regular usage.
Transport
- Transport the discs in a cold chain. Do not accept antimicrobial discs from suppliers/vendors if it is not received in an ice pack.
- Up on the receipt of the discs, immediately store them at 2 to 8**°C. If you are not using them soon, store discs at -20°**C.
Storage
- The antibiotic discs must be stored according to the manufacturer’s instructions, i.e., between -20°C and+ 8°C in a sealed, desiccated environment until needed.
- Sealed packages of disks that contain drugs from the ß-lactam class should be stored frozen, except for a small working supply, which may be refrigerated for at most one week.
- Some labile agents (e.g., imipenem, cefaclor, and clavulanic acid combinations) may retain excellent stability if stored frozen until the day of use.
Practice During Regular Usage
- Use only those discs that have not reached the manufacturer’s expiration date stated on the label. Discard the discs on the expiration date.
- Once a cartridge of discs has been removed from its sealed package, place it in a tightly sealed, desiccated container.
- Remove unopened disc containers from the refrigerator or freezerone to two hours before use.
- Allow unopened or used cartridges containing discs to equilibrate to room temperature before opening. This procedure minimizes the amount of condensation that occurs when warm air contacts cold disks.
- Even when the discs are removed, it should be made sure that they are not left out for too long.
- If a burner is used in your workplace, do not place antimicrobial discs around the vicinity of the burner.
Disc-dispensing apparatus
- Disc-dispensing apparatus should be fitted with a tight cover and supplied with an adequate desiccant.
- Allow the dispenser to warm to room temperature before opening. Excessive moisture should be avoided by replacing the desiccant when the indicator changes color.
- Always refrigerate dispensing apparatus containing discs when not in use.
References
- Balouiri, M., Sadiki, M., & Ibnsouda, S. K. (2016). Methods for in vitro evaluating antimicrobial activity: A review. Journal of pharmaceutical analysis, 6(2), 71–79. https://doi.org/10.1016/j.jpha.2015.11.005
- CLSI: Performance Standards for Antimicrobial Susceptibility Testing.
Related Posts
Martin Lewis Agar: Principle, Composition, and Uses
•Ashma Shrestha•bacteriology
Extremophiles: Their Types and Applications
•Ashma Shrestha•bacteriology
Fermented Foods: Types, Examples, and Health Benefits
•Aastha Shrestha•bacteriology
Prebiotics: Mechanisms, Sources, and Examples
•Aastha Shrestha•bacteriology